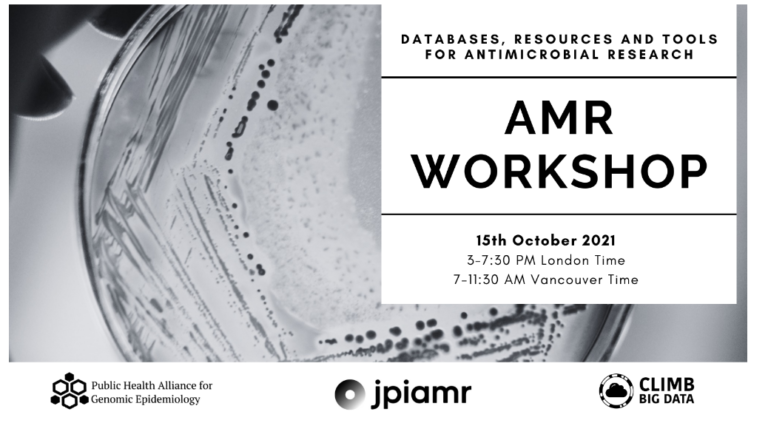

This publication describes the development of a standardized output specification and the hAMRonization tool to harmonise antimicrobial resistance (AMR) detection results across diverse bioinformatic tools. Developed with international public health laboratories, hAMRonization enables interoperable, unified AMR reporting and supports scalable integration into genomic surveillance workflows.